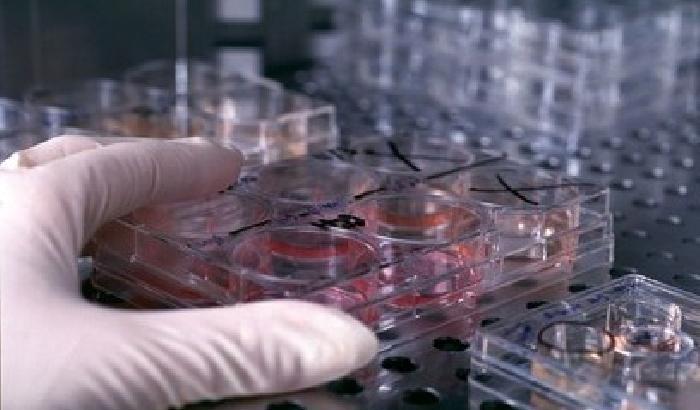
Cellule staminali efficaci contro le malattie della vista

I ricercatori dell’Inmi Spallanzani di Roma hanno isolato il virus Sars-CoV-2 nelle lacrime di una paziente. “Il virus è quindi attivo anche nelle secrezioni oculari dei pazienti positivi al virus e potenzialmente infettivo nelle lacrime anche quando i campioni respiratori della paziente, a tre settimane dal ricovero, risultavano ormai negativi”. E’ la conclusione a cui sono arrivati i ricercatori dello Spallanzani in un ricerca pubblicata su ‘Annals of Internal Medicine’.
Partendo da un tampone oculare prelevato tre giorni dopo il ricovero da una paziente positiva al virus, ricoverata allo Spallanzani alla fine di gennaio e che presentava una congiuntivite bilaterale, i ricercatori dello Spallanzani sono riusciti ad isolare il virus, dimostrando così che esso, oltre che nell’apparato respiratorio, è in grado di replicarsi anche nelle congiuntive. “Si tratta di una scoperta che ha importanti implicazioni anche sul piano della salute pubblica – evidenziano i ricercatori – tant’è che il risultato è stato comunicato all’Organizzazione mondiale della sanità d’accordo con l’Editor della rivista prima della pubblicazione”. La ricerca dello Spallanzani ha inoltre evidenziato “che i tamponi oculari possono essere positivi quando invece i campioni del distretto respiratorio non mostrano più tracce del virus”, precisano gli scienziati.
“Questa ricerca dimostra che gli occhi non sono soltanto una delle porte di ingresso del virus nell’organismo, ma anche una potenziale fonte di contagio – osserva Concetta Castilletti, responsabile dell’Unità Operativa Virus Emergenti del Laboratorio di Virologia dello Spallanzani – ne deriva la necessità di un uso appropriato di dispositivi di protezione in situazioni, quali gli esami oftalmici, che si pensava potessero essere relativamente sicure rispetto ai rischi di contagio che pone questo virus”.
Saranno necessari ulteriori studi “per verificare fino a quando il virus continua ad essere attivo e potenzialmente infettivo nelle lacrime: va ricordato infatti che l’analisi molecolare – conclude la ricerca – rileva soltanto la presenza del Rna virale nel campione, e soltanto l’isolamento del virus in una coltura cellulare può evidenziare la sua capacità infettante”.
Argomenti: covid-19